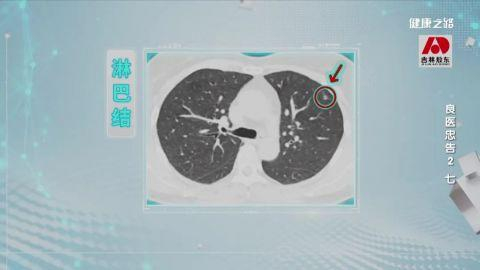

什么样的人需要去做CT检查?
肺上长了结节
究竟是不是得癌了?
气胸是如何发生的?
掌握蛛丝马迹
将肺部疾病一网打尽
肺癌早发现
CT很重要

什么样的人
需要去做CT检查?

CT检查虽有效,但辐射对人体是有害的。每天一包烟抽20年,每天两包烟抽10年和有肺癌家族史的这三类人群属于高危人群,专家建议每年进行一次低剂量螺旋CT筛查。
发现肺癌能够治愈吗?

相当比例的肺癌是可以治愈的,而且发现越早,治愈的机会越大。微创手段和传统手段最大的区别是,不用再把肋骨掰开,只需要一个小小的切口,即可完成肺部里面所有的操作。与开胸手术相比,微创手术不仅能减少患者的痛苦,而且也更加安全。
肺结节
离肺癌远着呢

肺结节和肺癌还是有一定的距离的。肺结节实际上是肺里有一些密度比肺组织高的一些组织,在CT上展现为肺结节的样子。
肺内淋巴结是身体一个正常的免疫器官,但有的人因为抽烟或炎症,可能会导致淋巴结增大。一般来说,肺内的淋巴结直径在1厘米左右,周围有像细线一样的结构,呈多边形状。在长期随访中,一般不会有明显的增大或减小。

还有一种良性结节是肺内的炎症。肺内的炎症通常是因为以前得过肺炎导致肺内的反应性的增生,在胸部CT上表现出密度增高影像,比较典型的特点是会呈现出一种云雾状。给患者服用抗生素,结节就会明显地消散和变小。

年轻的时候得过结核,或者说既往有分枝杆菌感染的表现,在肺窗上看,结节有一些毛刺和一点点的分叶,甚至还能看到一些胸膜的牵拉,形态上跟肺癌有一些类似。但是调到纵隔窗,就会发现在红色圆圈的中间有一点钙化,这种可能是结核瘤,是良性病灶的表现。
长了肺结节
要每年定期复查吗?

如果每年复查肺结节没有明显的变化,两年以后可以适当拉开复查的间隔,甚至可以回到像正常人一样的间隔。对于45岁以上有高危因素的患者,即使两年都没有变化,还是应该按照正常的肺癌筛查的频率,每年做复查。
肺结节发生了什么变化
要提高警惕呢?

结节有了明显的毛刺和分叶表现,而且还有一些胸膜牵拉的表现,是恶性的可能性比较大。肺结节的生长速度也需要重点关注。一般来说,结节的体积如果在400天内增长一倍的话,这些结节有可能是恶性的。
青少年突发胸痛
小心肺破了

气胸,简单来说就是胸腔里积了气,肺部受到不同程度的压迫。气体来源于外界的空气,比如胸部刀扎伤,叫做创伤性气胸。还有一种叫自发性气胸,就是肺破了,肺里的气体跑到了胸腔里面。
气胸的胸痛
有什么特点吗?

引起胸痛的原因有很多,气胸造成的胸痛是有独特点的。首先是突然发作,其次往往发于单侧,疼痛感是针刺样和撕扯样的。最主要是胸痛会伴随着喘憋和呼吸困难。
专家提示
15岁到30岁是气胸的高发年龄,青少年需高度警惕。
运动量过大
会引发气胸吗?

气胸和运动量大小没有必然的联系。第一,瘦高体形的男生容易得气胸,因为瘦高体形的男生胸廓狭长,肺尖部承受的负压最大。第二,有气胸家族史的人容易得气胸。第三,气胸会反复发作,得过一次后,可能还会得。
(CCTV健康之路)


